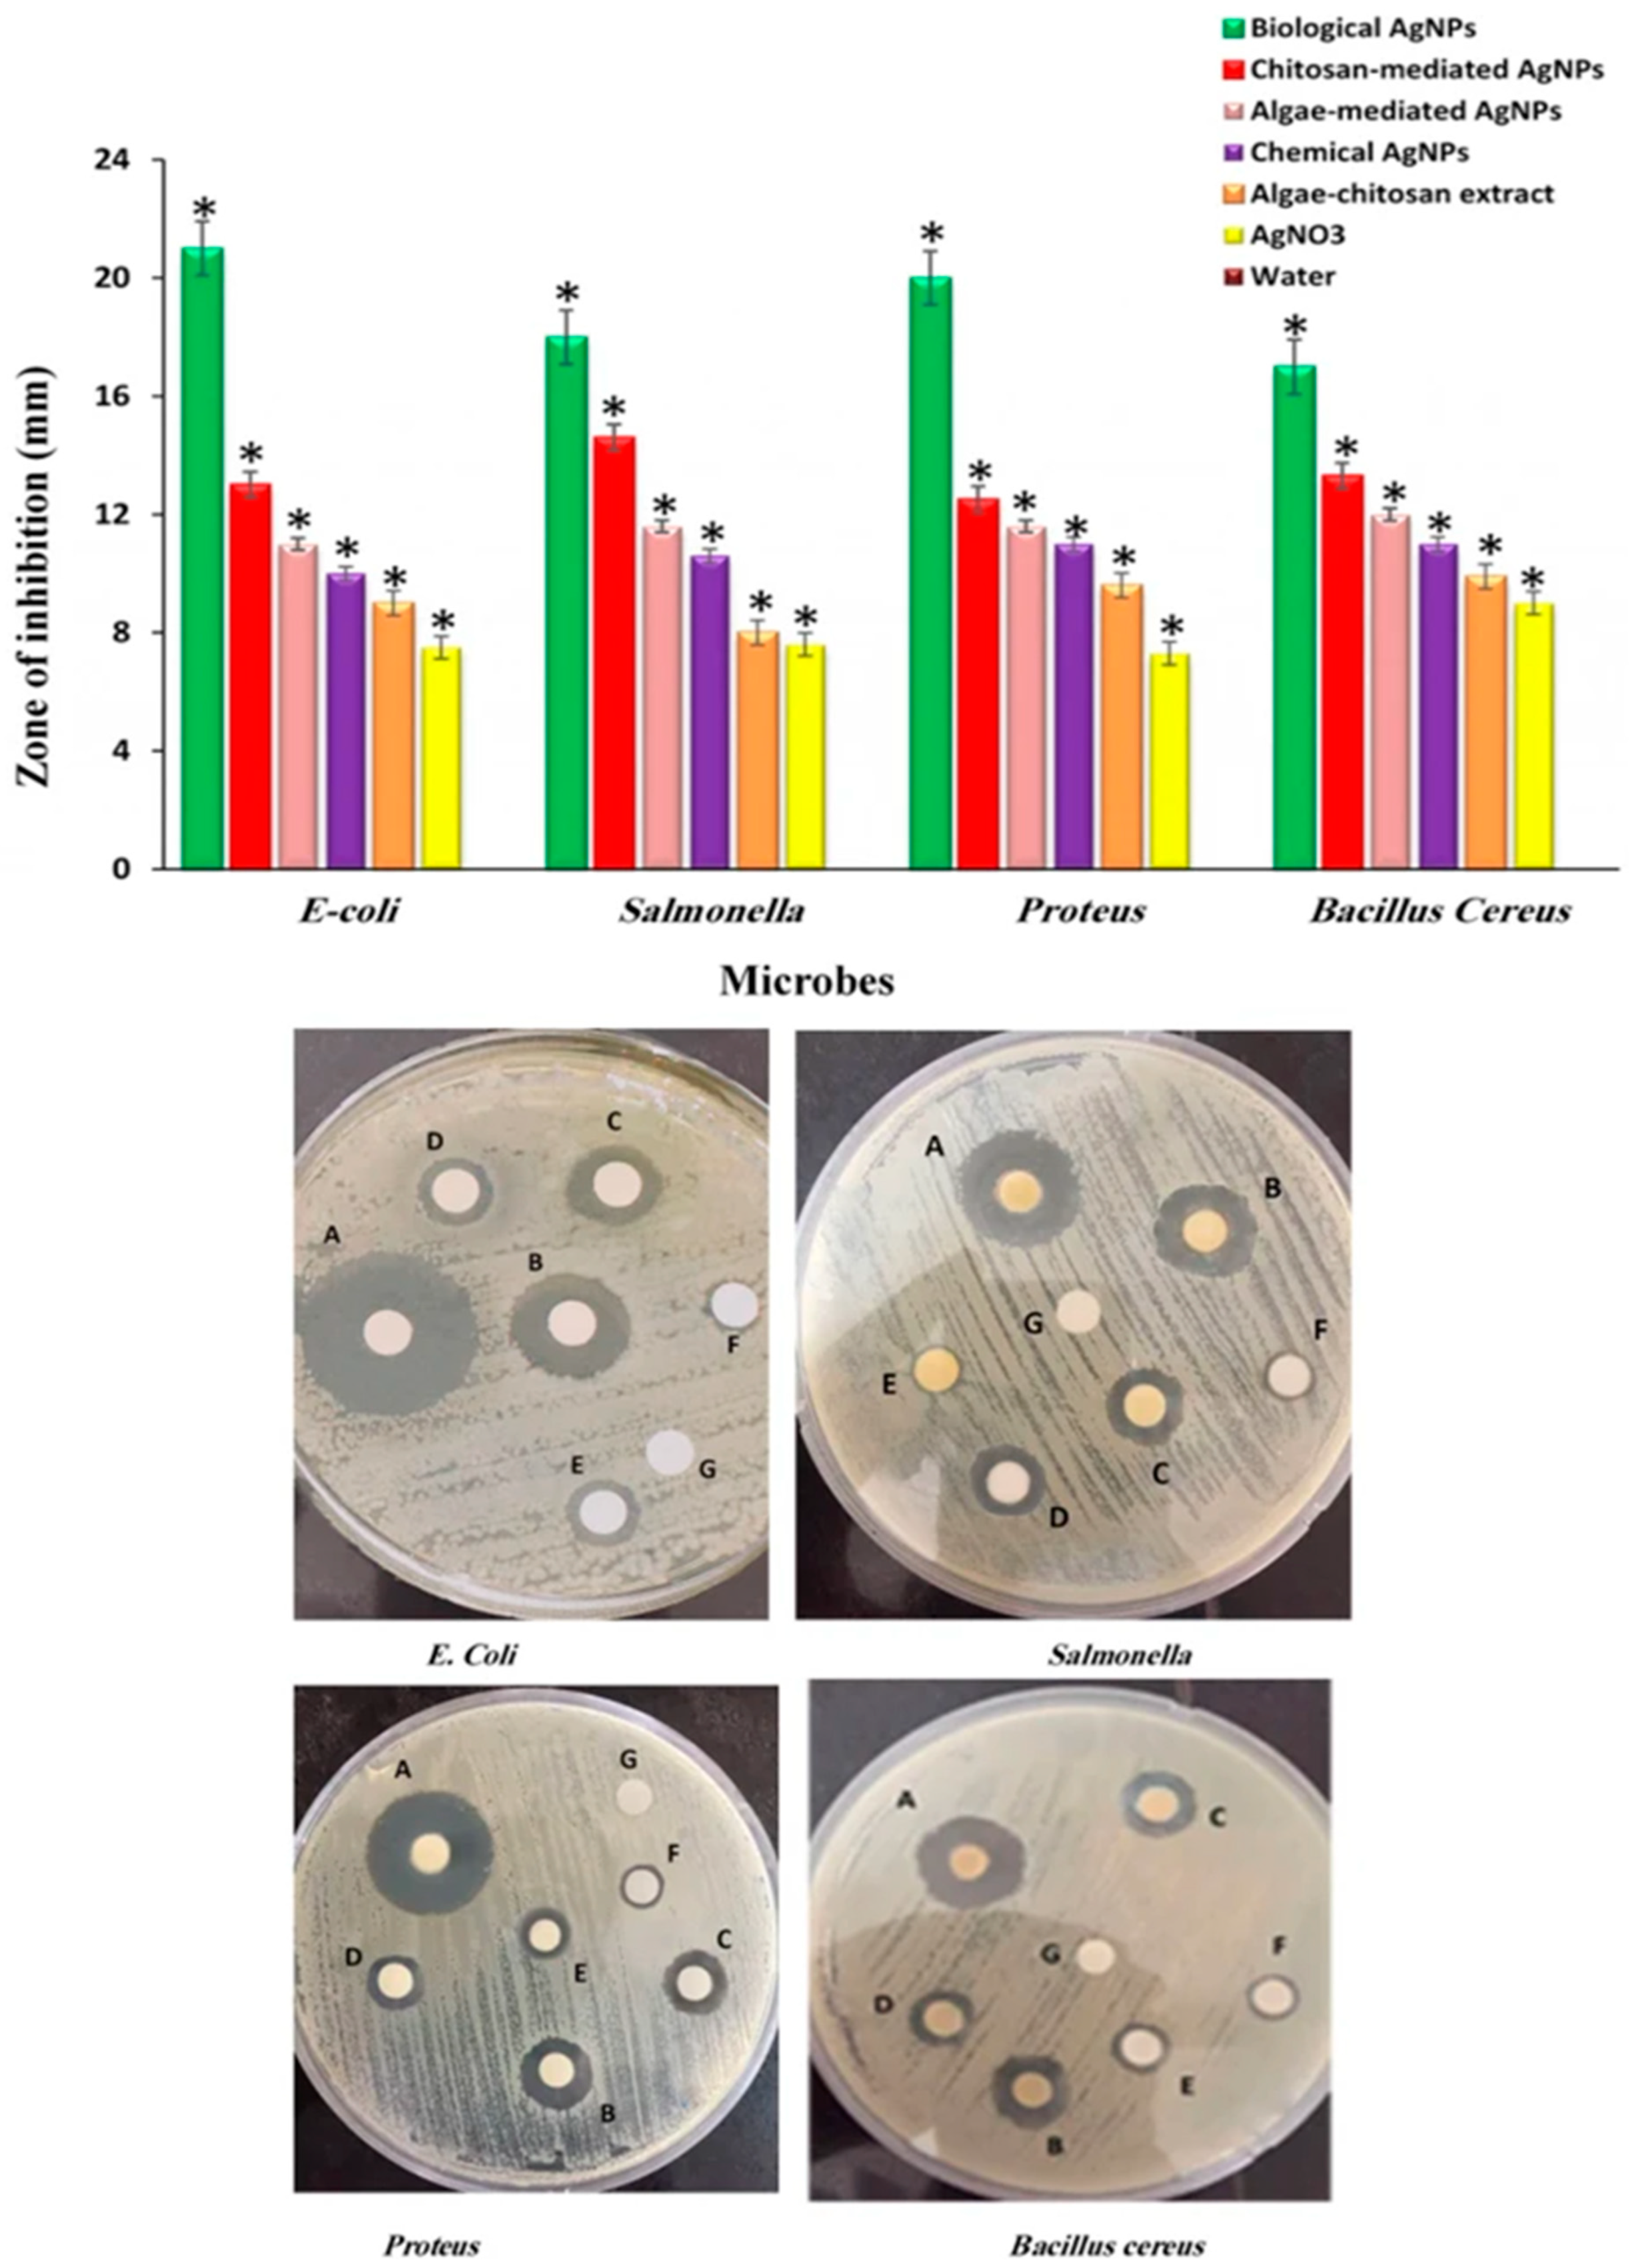
Polymers 14 05302 g004

Chitosan-Coated Polymeric Silver and Gold Nanoparticles: Biosynthesis, Characterization and Potential Antibacterial Applications: A Review
Abstract
1. Introduction
2. Biosynthesis of Ch-Coated Polymeric Silver and Gold Nanoparticles
2.1. Plant-Mediated Biosynthesis
2.2. Microbe-Mediated Biosynthesis
3. Characterization of Synthesized Ch-Coated Polymeric Silver and Gold Nanoparticles
4. Potential Antibacterial Applications of Ch-Coated Polymeric Silver and Gold Nanoparticles
5. Antibacterial Mechanisms of Ch-Coated Polymeric Silver and Gold Nanoparticles
6. Conclusions and Future Perspectives
Author Contributions
Funding
Institutional Review Board Statement
Informed Consent Statement
Data Availability Statement
Conflicts of Interest
References
- Singh, P.; Mijakovic, I. Green synthesis and antibacterial applications of gold and silver nanoparticles from Ligustrum vulgare berries. Sci. Rep. 2022, 12, 7902. [Google Scholar] [CrossRef] [PubMed]
- Huq, M.A.; Ashrafudoulla, M.; Rahman, M.M.; Balusamy, S.R.; Akter, S. Green synthesis and potential antibacterial applications of bioactive silver nanoparticles: A review. Polymers 2022, 14, 742. [Google Scholar] [PubMed]
- Majdalawieh, A.; Kanan, M.C.; El-Kadri, O. Recent advances in gold and silver nanoparticles: Synthesis and applications. J. Nanosci. Nanotechnol. 2014, 14, 4757–4780. [Google Scholar]
- Singh, P.; Kim, Y.J.; Singh, H. Biosynthesis, characterization, and antimicrobial applications of silver nanoparticles. Int. J. Nanomed. 2015, 10, 2567–2577. [Google Scholar]
- Huq, M.A.; Akter, S. Characterization and genome analysis of Arthrobacter bangladeshi sp. nov., applied for the green synthesis of silver nanoparticles and their antibacterial efficacy against drug-resistant human pathogens. Pharmaceutics 2021, 13, 1691. [Google Scholar]
- Zazo, H.; Colino, C.I.; Lanao, J.M. Current applications of nanoparticles in infectious diseases. J. Control. Release 2016, 224, 86–102. [Google Scholar]
- Farhadian, N.; Mashoof, R.U.; Khanizadeh, S. Streptococcus mutans counts in patients wearing removable retainers with silver nanoparticles vs those wearing conventional retainers: A randomized clinical trial. Am. J. Orthod. Dentofac. Orthop. 2016, 149, 155–160. [Google Scholar]
- Huq, M.A.; Akter, S. Bacterial mediated rapid and facile synthesis of silver nanoparticles and their antimicrobial efficacy against pathogenic microorganisms. Materials 2021, 14, 2615. [Google Scholar] [PubMed]
- Wang, X.; Lee, S.-Y.; Akter, S.; Huq, M.A. Probiotic-mediated biosynthesis of silver nanoparticles and their antibacterial applications against pathogenic strains of Escherichia coli O157:H7. Polymers 2022, 14, 1834. [Google Scholar] [CrossRef] [PubMed]
- Chaloupka, K.; Malam, Y.; Seifalian, A.M. Nanosilver as a new generation of nanoproduct in biomedical applications. Trends Biotechnol. 2010, 28, 580–588. [Google Scholar]
- Ahmed, S.; Ahmad, M.; Swami, B.L.; Ikram, S. A review on plants extract mediated synthesis of silver nanoparticles for antimicrobial applications: A green expertise. J. Adv. Res. 2016, 7, 17–28. [Google Scholar] [CrossRef] [PubMed]
- Huq, M.A.; Akter, S. Biosynthesis, characterization and antibacterial application of novel silver nanoparticles against drug resistant pathogenic Klebsiella pneumoniae and Salmonella Enteritidis. Molecules 2021, 26, 5996. [Google Scholar] [CrossRef]
- Ge, L.; Li, Q.; Wang, M.; Ouyang, J.; Li, X.; Xing, M.M. Nanosilver particles in medical applications: Synthesis, performance, and toxicity. Int. J. Nanomed. 2014, 16, 2399–2407. [Google Scholar]
- Ovais, M.; Ahmad, I.; Khalil, A.T.; Mukherjee, S.; Javed, R.; Ayaz, M.; Raza, A.; Shinwari, Z.K. Wound healing applications of biogenic colloidal silver and gold nanoparticles: Recent trends and future prospects. Appl. Microbiol. Biotechnol. 2018, 102, 4305–4318. [Google Scholar] [CrossRef]
- Benyettou, F.; Rezgui, R.; Ravaux, F. Synthesis of silver nanoparticles for the dual delivery of doxorubicin and alendronate to cancer cells. J. Mater. Chem. B. 2015, 3, 7237–7245. [Google Scholar] [CrossRef] [PubMed]
- Brown, P.K.; Qureshi, A.T.; Moll, A.N.; Hayes, D.J.; Monroe, W.T. Silver nanoscale antisense drug delivery system for photoactivated gene silencing. ACS. Nano 2013, 7, 2948–2959. [Google Scholar] [CrossRef] [PubMed]
- Zhou, W.; Ma, Y.; Yang, H.; Ding, Y.; Luo, X. A label-free biosensor based on silver nanoparticles array for clinical detection of serum p53 in head and neck squamous cell carcinoma. Int. J. Nanomed. 2011, 6, 381–386. [Google Scholar] [CrossRef]
- Gomes, H.I.O.; Martins, C.S.M.; Prior, J.A.V. Silver Nanoparticles as Carriers of Anticancer Drugs for Efficient Target Treatment of Cancer Cells. Nanomaterials 2021, 11, 964. [Google Scholar] [CrossRef]
- Tiwari, P.M.; Vig, K.; Dennis, V.A.; Singh, S.R. Functionalized gold nanoparticles and their biomedical applications. Nanomaterials 2011, 1, 31–63. [Google Scholar] [CrossRef]
- Jeyarani, S.; Vinita, N.M.; Puja, P.; Senthamilselvi, S.; Devan, U.; Velangani, A.J.; Biruntha, M.; Pugazhendhi, A.; Kumar, P. Biomimetic gold nanoparticles for its cytotoxicity and biocompatibility evidenced by fluorescence-based assays in cancer (MDA-MB-231) and non-cancerous (HEK-293) cells. J. Photochem. Photobiol. B 2020, 202, 111715. [Google Scholar] [CrossRef]
- Cho, K.; Wang, X.U.; Niem, S.; Shin, D.M. Therapeutic nanoparticles for drug delivery in cancer. Clin. Cancer Res. 2008, 14, 1310–1316. [Google Scholar] [CrossRef]
- Kumar, A.; Zhang, X.; Liang, X.J. Gold nanoparticles: Emerging paradigm for targeted drug delivery system. Biotechnol. Adv. 2013, 31, 593–606. [Google Scholar] [CrossRef] [PubMed]
- Mieszawska, A.J.; Mulder, W.J.; Fayad, Z.A.; Cormode, D.P. Multifunctional gold nanoparticles for diagnosis and therapy of disease. Mol. Pharm. 2013, 10, 831–847. [Google Scholar] [CrossRef] [PubMed]
- Zhang, L.; Gu, F.X.; Chan, J.M.; Wang, A.Z.; Langer, R.S.; Farokhzad, O.C. Nanoparticles in medicine: Therapeutic applications and developments. Clin. Pharmacol. Ther. 2007, 83, 761–769. [Google Scholar] [CrossRef] [PubMed]
- Khan, A.U.; Yuana, Q.; Weia, Y. Photocatalytic and antibacterial response of biosynthesized gold nanoparticles. J. Photochem. Photobiol. B Biol. 2016, 162, 172–177. [Google Scholar] [CrossRef]
- Kumar-Krishnan, S.; Prokhorov, E.; Hernández-Iturriaga, M.; Mota-Morales, J.D.; Vázquez-Lepe, M.; Kovalenko, Y.; Sanchez, I.C.; Luna-Bárcenas, G. Chitosan/silver nanocomposites: Synergistic antibacterial action of silver nanoparticles and silver ions. Eur. Polym. J. 2015, 67, 242–251. [Google Scholar] [CrossRef]
- Fuster, M.G.; Montalbán, M.G.; Carissimi, G.; Lima, B.; Feresin, G.E.; Cano, M.; Giner-Casares, J.J.; López-Cascales, J.J.; Enriz, R.D.; Víllora, G. Antibacterial Effect of Chitosan-Gold Nanoparticles and Computational Modeling of the Interaction between Chitosan and a Lipid Bilayer Model. Nanomaterials 2020, 10, 2340. [Google Scholar] [CrossRef]
- Sanpui, P.; Murugadoss, A.; Prasad, P.V.D.; Ghosh, S.S.; Chattopadhyay, A. The Antibacterial Properties of a Novel Chitosan-Ag-Nanoparticle Composite. Int. J. Food Microbiol. 2008, 124, 142–146. [Google Scholar] [CrossRef]
- Ke, C.L.; Deng, F.S.; Chuang, C.Y.; Lin, C.H. Antimicrobial Actions and Applications of Chitosan. Polymers 2021, 13, 904. [Google Scholar] [CrossRef]
- Shih, P.Y.; Liao, Y.T.; Tseng, Y.K.; Deng, F.S.; Lin, C.H. A Potential Antifungal Effect of Chitosan Against Candida albicans Is Mediated via the Inhibition of SAGA Complex Component Expression and the Subsequent Alteration of Cell Surface Integrity. Front. Microbiol. 2019, 10, 602. [Google Scholar] [CrossRef]
- El-Naggar, N.E.-A.; Saber, W.I.A.; Zweil, A.M.; Bashir, S.I. An innovative green synthesis approach of chitosan nanoparticles and their inhibitory activity against phytopathogenic Botrytis cinerea on strawberry leaves. Sci. Rep. 2022, 12, 3515. [Google Scholar] [CrossRef] [PubMed]
- Abdelhamid, H.N.; El-Ber, H.M.; Metwally, A.A.; Elshazl, M.; Hathout, R.M. Synthesis of CdS-modified chitosan quantum dots for the drug delivery of Sesamol. Carbohdrate Polym. 2019, 214, 90–99. [Google Scholar] [CrossRef] [PubMed]
- Panda, P.K.; Sadeghi, K.; Seo, J. Recent advances in poly (vinyl alcohol)/natural polymer based films for food packaging applications: A review. Food Packag. Shelf Life 2022, 33, 100904. [Google Scholar] [CrossRef]
- Panda, P.K.; Yang, J.-M.; Chang, Y.-H.; Su, W.-W. Modification of different molecular weights of chitosan by p-Coumaric acid: Preparation, characterization and effect of molecular weight on its water solubility and antioxidant property. Int. J. Biol. Macromol. 2019, 136, 661–667. [Google Scholar] [CrossRef] [PubMed]
- Fernández-Pan, I.; Maté, J.I.; Gardrat, C.; Coma, V. Effect of chitosan molecular weight on the antimicrobial activity and release rate of carvacrol-enriched flms. Food Hydrocoll. 2015, 51, 60–68. [Google Scholar] [CrossRef]
- Hashem, A.H.; Shehabeldine, A.M.; Ali, O.M.; Salem, S.S. Synthesis of Chitosan-Based Gold Nanoparticles: Antimicrobial and Wound-Healing Activities. Polymers 2022, 14, 2293. [Google Scholar] [CrossRef]
- Corbierre, M.K.; Cameron, N.S.; Lennox, R.B. Polymer-stabilized gold nanoparticles with high grafting densities. Langmuir 2004, 20, 2867–2873. [Google Scholar] [CrossRef] [PubMed]
- DeLong, R.K.; Reynolds, C.M.; Malcolm, Y.; Schaeffer, A.; Severs, T.; Wanekaya, A. Functionalized gold nanoparticles for the binding, stabilization, and delivery of therapeutic DNA, RNA, and other biological macromolecules. Nanotechnol. Sci. Appl. 2010, 3, 53–63. [Google Scholar] [CrossRef]
- Chompoosor, A.; Han, G.; Rotello, V.M. Charge dependence of ligand release and monolayer stability of gold nanoparticles by biogenic thiols. Bioconjug. Chem. 2008, 19, 1342–1345. [Google Scholar] [CrossRef]
- Infectious Diseases Society of America (IDSA). Combating antimicrobial resistance: Policy recommendations to save lives. Clin. Infect. Dis. 2011, 52, 397–428. [Google Scholar] [CrossRef]
- Perez, F.; van-Duin, D. Carbapenem-resistant Enterobacteriaceae: A menace to our most vulnerable patients. Clevel. Clin. J. Med. 2013, 80, 225–233. [Google Scholar] [CrossRef]
- Neut, C. Carriage of Multidrug-Resistant Bacteria in Healthy People: Recognition of Several Risk Groups. Antibiotics 2021, 10, 1163. [Google Scholar] [CrossRef]
- Huq, M.A. Green synthesis of silver nanoparticles using Pseudoduganella eburnea MAHUQ-39 and their antimicrobial mechanisms investigation against drug-resistant human pathogens. Int. J. Mol. Sci. 2020, 21, 1510. [Google Scholar] [CrossRef]
- Hasan, K.M.F.; Wang, H.; Mahmud, S.; Genyang, C. Coloration of aramid fabric via in-situ biosynthesis of silver nanoparticles with enhanced antibacterial effect. Inorg. Chem. Commun. 2022, 119, 108115. [Google Scholar] [CrossRef]
- Akter, S.; Huq, M.A. Biologically rapid synthesis of silver nanoparticles by Sphingobium sp. MAH-11T and their antibacterial activity and mechanisms investigation against drug-resistant pathogenic microbes. Artif. Cells Nanomed. Biotechnol. 2020, 48, 672–682. [Google Scholar] [CrossRef]
- Shinde, S.; Folliero, V.; Chianese, A.; Zannella, C.; De Filippis, A.; Rosati, L.; Prisco, M.; Falanga, A.; Mali, A.; Galdiero, M.; et al. Synthesis of chitosan-coated silver nanoparticle bioconjugates and their antimicrobial activity against multidrug-resistant bacteria. Appl. Sci. 2021, 11, 9340. [Google Scholar] [CrossRef]
- Saha, S.K.; Roy, P.; Mondal, M.K.; Roy, D.; Gayen, P.; Chowdhury, P.; Babu, S.P.S. Development of chitosan based gold nanomaterial as an efficient antifilarial agent: A mechanistic approach. Carbohydr. Polym. 2017, 157, 1666–1676. [Google Scholar] [CrossRef]
- Fouda, A.; Abdel-Maksoud, G.; Abdel-Rahman, M.A.; Salem, S.S.; Hassan, S.E.D.; El-Sadany, M.A.H. Eco-friendly approach utilizing green synthesized nanoparticles for paper conservation against microbes involved in biodeterioration of archaeological manuscript. Int. Biodeterior. Biodegrad. 2019, 142, 160–169. [Google Scholar] [CrossRef]
- Iravani, S.; Korbekandi, H.; Mirmohammadi, S.V.; Zolfaghari, B. Synthesis of silver nanoparticles: Chemical, physical and biological methods. Res. Pharm. Sci. 2014, 9, 385–406. [Google Scholar]
- Ghetas, H.A.; Abdel-Razek, N.; Shakweer, M.S.; Abotaleb, M.M.; Ahamad-Paray, B.; Ali, S.; Eldessouki, E.A.; Dawood, M.A.O.; Khalil, R.H. Antimicrobial activity of chemically and biologically synthesized silver nanoparticles against some fish pathogens. Saudi J. Biol. Sci. 2022, 29, 1298–1305. [Google Scholar] [CrossRef]
- Paulkumar, K.; Gnanajobitha, G.; Vanaja, M.; Pavunraj, M.; Annadurai, G. Green synthesis of silver nanoparticle and silver based chitosan bionanocomposite using stem extract of Saccharum officinarum and assessment of its antibacterial activity. Adv. Nat. Sci. Nanosci. Nanotechnol. 2017, 8, 035019. [Google Scholar] [CrossRef]
- Du, J.; Sing, H.; Yi, T.H. Antibacterial, anti-biofilm and anticancer potentials of green synthesized silver nanoparticles using benzoin gum (Styrax benzoin) extract. Bioprocess Biosyst. Eng. 2016, 39, 1923–1931. [Google Scholar] [CrossRef]
- Rajeshkumar, S.; Tharani, M.; Rajeswari, V.D.; Alharbi, N.S.; Kadaikunnan, S.; Khaled, J.M.; Gopinath, K.; Vijayakumar, N.; Govindarajan, M. Synthesis of greener silver nanoparticle-based chitosan nanocomposites and their potential antimicrobial activity against oral pathogens. Green Process. Synth. 2021, 10, 658–665. [Google Scholar] [CrossRef]
- Raza, S.; Ansari, A.; Siddiqui, N.N.; Ibrahim, F.; Abro, M.I.; Aman, A. Biosynthesis of silver nanoparticles for the fabrication of non cytotoxic and antibacterial metallic polymer based nanocomposite system. Sci. Rep. 2021, 11, 10500. [Google Scholar] [CrossRef]
- Ramesh, V.; John, S.A.; Koperuncholan, M. Impact of cement industries dust on selective green plants: A case study in Ariyalur industrial zone. Int. J. Pharm. Chem. Biol. Sci. 2014, 4, 152–158. [Google Scholar]
- Singh, P.; Kim, Y.J.; Zhang, D.; Yang, D.C. Biological synthesis of nanoparticles from plants and microorganisms. Trends Biotechnol. 2016, 34, 588–599. [Google Scholar] [CrossRef]
- Sukweenadhi, J.; Setiawan, K.I.; Avanti, C.; Kartini, K.; Rupa, E.J.; Yang, D.C. Scale-up of green synthesis and characterization of silver nanoparticles using ethanol extract of Plantago major L. leaf and its antibacterial potential. S. Afr. J. Chem. Eng. 2021, 38, 1–8. [Google Scholar] [CrossRef]
- Sathiyaseelan, A.; Shajahan, A.; Kalaichelvan, P.T.; Kaviyarasan, V. Fungal chitosan based nanocomposites sponges-An alternative medicine for wound dressing. Int. J. Biol. Macromol. 2017, 104, 1905–1915. [Google Scholar] [CrossRef]
- Saruchi; Kaur, M.; Kumar, V.; Ghfar, A.A.; Pandey, S. A Green Approach for the Synthesis of silver nanoparticle-embedded chitosan bionanocomposite as a potential device for the sustained release of the itraconazole drug and its antibacterial characteristics. Polymers 2022, 14, 1911. [Google Scholar] [CrossRef]
- Badawy, M.E.I.; Lotfy, T.M.R.; Shawir, S.M.S. Preparation and antibacterial activity of chitosan-silver nanoparticles for application in preservation of minced meat. Bull. Natl. Res. Cent. 2019, 43, 83. [Google Scholar] [CrossRef]
- Mirda, E.; Idroes, R.; Khairan, K.; Tallei, T.E.; Ramli, M.; Earlia, N.; Maulana, A.; Idroes, G.M.; Muslem, M.; Jalil, Z. Synthesis of chitosan-silver nanoparticle composite spheres and their antimicrobial activities. Polymers 2021, 13, 3990. [Google Scholar] [CrossRef] [PubMed]
- Kalaivani, R.; Maruthupandy, M.; Muneeswaran, T.; Hameedha-Beevi, A.; Anand, M.; Ramakritinan, C.M.; Kumaraguru, A.K. Synthesis of chitosan mediated silver nanoparticles (AgNPs) for potential antimicrobial applications. Front. Lab. Med. 2018, 2, 30–35. [Google Scholar] [CrossRef]
- Kulikouskaya, V.; Hileuskaya, K.; Kraskouski, A.; Kozerozhets, I.; Stepanova, E.; Kuzminski, I.; You, L.; Agabekov, V. Chitosan-capped silver nanoparticles: A comprehensive study of polymer molecular weight effect on the reaction kinetic, physicochemical properties, and synergetic antibacterial potential. SPE. Polymers 2022, 3, 77–90. [Google Scholar] [CrossRef]
- Dara, P.K.; Mahadevan, R.; Digita, P.A.; Visnuvinayagam, S.; Kumar, L.R.G.; Mathew, S.; Ravishankar, C.N.R.; Anandan, R. Synthesis and biochemical characterization of silver nanoparticles grafted chitosan (Chi-Ag-NPs): In vitro studies on antioxidant and antibacterial applications. SN Appl. Sci. 2020, 2, 665. [Google Scholar] [CrossRef]
- Bonilla, J.J.A.; Honorato, L.; Guimarães, A.J.; Miranda, K.; Nimrichter, L. Silver Chitosan Nanocomposites are Effective to Combat Sporotrichosis. Front. Nanotechnol. 2022, 4, 857681. [Google Scholar] [CrossRef]
- Regielfutyra, A.; Kusliśkiewicz, M.; Sebastian, V.; Irusta, S.; Arruebo, M.; Kyzioł, A.; Stochel, G. Development of noncytotoxic silver–chitosan nanocomposites for efficient control of biofilm forming microbes. RSC Adv. 2017, 7, 52398–52413. [Google Scholar] [CrossRef]
- Venkatesham, M.; Ayodhya, D.; Madhusudhan, A.; Veera Babu, N.; Veerabhadram, G. A novel green one-step synthesis of silver nanoparticles using chitosan: Catalytic activity and antimicrobial studies. Appl. Nanosci. 2014, 4, 113–119. [Google Scholar] [CrossRef]
- Priya, K.; Vijayakumar, M.; Janani, B. Chitosan-mediated synthesis of biogenic silver nanoparticles (AgNPs), nanoparticle characterisation and in vitro assessment of anticancer activity in human hepatocellular carcinoma HepG2 cells. Int. J. Biol. Macromol. 2020, 149, 844–852. [Google Scholar] [CrossRef]
- Samanta, S.; Banerjee, J.; Das, B.; Mandal, J.; Chatterjee, S.; Ali, K.M.; Sinha, S.; Giri, B.; Ghosh, T.; Dash, S.K. Antibacterial Potency of Cytocompatible Chitosan-Decorated Biogenic Silver Nanoparticles and Molecular Insights towards Cell-Particle Interaction. Int. J. Biol. Macromol. 2022, 219, 919–939. [Google Scholar] [CrossRef]
- Kanniah, P.; Chelliah, P.; Thangapandi, J.R.; Gnanadhas, G.; Mahendran, V.; Robert, M. Green synthesis of antibacterial and cytotoxic silver nanoparticles by Piper nigrum seed extract and development of antibacterial silver based chitosan nanocomposite. Int. J. Biol. Macromol. 2021, 189, 18–33. [Google Scholar] [CrossRef]
- Youssef, A.M.; Mohamed, S.; Abdel-Aziz, S. Chitosan nanocomposite films based on Ag-NP and Au-NP biosynthesis by Bacillus Subtilis as packaging materials. Int. J. Biol. Macromol. 2014, 69, 185–191. [Google Scholar] [CrossRef]
- Mostafa, E.M.; Abdelgawad, M.A.; Musa, A.; Alotaibi, N.H.; Elkomy, M.H.; Ghoneim, M.M.; Badawy, M.S.E.M.; Taha, M.N.; Hassan, H.M.; Hamed, A.A. Chitosan Silver and Gold Nanoparticle Formation Using Endophytic Fungi as Powerful Antimicrobial and Anti-Biofilm Potentialities. Antibiotics 2022, 11, 668. [Google Scholar] [CrossRef]
- Dananjaya, S.H.S.; Udayangani, R.M.C.; Nikapitiya, C.; Lee, J.; De-Zoysa, M. Green synthesis, physio-chemical characterization and anti-candidal function of a biocompatible chitosan gold nanocomposite as a promising antifungal therapeutic agent. RSC Adv. 2017, 7, 9182–9193. [Google Scholar] [CrossRef]
- Tomaszewska, E.; Soliwoda, K.; Kadziola, K.; Tkacz-Szczesna, B.; Celichowski, G.; Cichomski, M.; Szmaja, W.; Grobelny, J. Detection limits of DLS and UV-Vis spectroscopy in characterization of polydisperse nanoparticles colloids. J. Nanomater. 2013, 2013, 313081. [Google Scholar] [CrossRef]
- Ferri, M.; Ranucci, E.; Romagnoli, P.; Giaccone, V. Antimicrobial resistance: A global emerging threat to public health systems. Crit. Rev. Food Sci. 2017, 57, 2857–2876. [Google Scholar] [CrossRef]
- WHO. New Report Calls for Urgent Action to Avert Antimicrobial Resistance Crisis. Available online: https://www.who.int/news/item/29-04-2019-new-report-calls-for-urgent-action-to-avert-antimicrobial-resistance-crisis (accessed on 23 March 2022).
- Avadi, M.R.; Sadeghi, A.M.; Tahzibi, A.; Bayati, K.H.; Pouladzadeh, M.; Zohuriaan-mehr, M.J.; Rafiee-Tehrani, M. Diethylmethyl chitosan as an antimicrobial agent: Synthesis, characterization and antibacterial effects. Eur. Polym. J. 2004, 40, 1355–1361. [Google Scholar] [CrossRef]
- Costa, E.M.; Silva, S.; Pina, C.; Tavaria, F.K.; Pintado, M.M. Evaluation and insights into chitosan antimicrobial activity against anaerobic oral pathogens. Anaerobe 2012, 18, 305–309. [Google Scholar] [CrossRef]
- Jiang, L.; Wang, F.; Han, F.; Prinyawiwatkul, W.; No, H.K.; Ge, B. Evaluation of diffusion and dilution methods to determine the antimicrobial activity of water-soluble chitosan derivatives. J. Appl. Microbiol. 2013, 114, 956–963. [Google Scholar] [CrossRef]
- Mansilla, A.Y.; Albertengo, L.; Rodriguez, M.S.; Debbaudt, A.; Zuniga, A.; Casalongue, C.A. Evidence on antimicrobial properties and mode of action of a chitosan obtained from crustacean exoskeletons on Pseudomonas syringae pv. tomato DC3000. tomato DC3000. Appl. Microbiol. Biotechnol. 2013, 97, 6957–6966. [Google Scholar] [CrossRef]
- Ma, Z.X.; Garrido-Maestu, A.; Jeong, K.C. Application, mode of action, and in vivo activity of chitosan and its micro and nanoparticles as antimicrobial agents: A review. Carbohydr. Polym. 2017, 176, 257–265. [Google Scholar] [CrossRef]
- Akter, S.; Lee, S.-Y.; Siddiqi, M.Z.; Balusamy, S.R.; Ashrafudoulla, M.; Rupa, E.J.; Huq, M.A. Ecofriendly synthesis of silver nanoparticles by Terrabacter humi sp. nov. and their antibacterial application against antibiotic-resistant pathogens. Int. J. Mol. Sci. 2020, 21, 9746. [Google Scholar] [CrossRef]
- Huq, M.A. Biogenic Silver Nanoparticles Synthesized by Lysinibacillus xylanilyticus MAHUQ-40 to Control Antibiotic-Resistant Human Pathogens Vibrio parahaemolyticus and Salmonella Typhimurium. Front. Bioeng. Biotechnol. 2020, 8, 597502. [Google Scholar] [CrossRef]
- Sathiyaraj, S.; Suriyakala, G.; Dhanesh-Gandhi, A.; Babujanarthanam, R.; Almaary, K.S.; Chen, T.W.; Kaviyarasu, K. Biosynthesis, characterization, and antibacterial activity of gold nanoparticles. J. Infect. Public Health 2021, 14, 1842–1847. [Google Scholar] [CrossRef] [PubMed]
- Sabudin, S.; Derman, M.; Zainol, I.; Noorsal, K. In vitro cytotoxicity and cell seeding studies of a chitosan-silver composite for potential wound management applications. J. Eng. Sci. 2012, 8, 29–37. [Google Scholar]
- Katas, H.; Moden, N.Z.; Lim, C.S.; Celesistinus, T.; Chan, J.Y.; Ganasan, P.; Suleman Ismail Abdalla, S. Biosynthesis and potential applications of silver and gold nanoparticles and their chitosan-based nanocomposites in nanomedicine. J. Nanotechnol. 2018, 2018, 4290705. [Google Scholar] [CrossRef]
- Panda, P.K.; Dash, P.; Chang, Y.-H.; Yang, J.-M. Improvement of chitosan water solubility by fumaric acid modification. Mater. Lett. 2022, 316, 132046. [Google Scholar] [CrossRef]
- Katas, H.; Alpar, H.O. Development and Characterisation of Chitosan Nanoparticles for SiRNA Delivery. J. Control. Release 2006, 115, 216–225. [Google Scholar] [CrossRef]
- Potara, M.; Jakab, E.; Damert, A.; Popescu, O.; Canpean, V.; Astilean, S. Synergistic antibacterial activity of chitosan-silver nanocomposites on Staphylococcus aureus. Nanotechnology 2011, 22, 135101. [Google Scholar] [CrossRef] [PubMed]
- Rezazadeh, N.H.; Buazar, F.; Matroodi, S. Synergistic effects of combinatorial chitosan and polyphenol biomolecules on enhanced antibacterial activity of biofunctionalized silver nanoparticles. Sci. Rep. 2020, 10, 19615. [Google Scholar] [CrossRef]
- Devlieghere, F.; Vermeulen, A.; Debevere, J. Chitosan: Antimicrobial Activity, Interactions with Food Components and Applicability as a Coating on Fruit and Vegetables. Food Microbiol. 2004, 21, 703–714. [Google Scholar] [CrossRef]
- Sebti, I.; Martial-Gros, A.; Carnet-Pantiez, A.; Grelier, S.; Coma, V. Chitosan Polymer as Bioactive Coating and Film against Aspergillus niger Contamination. J. Food Sci. 2005, 70, M100–M104. [Google Scholar] [CrossRef]
- Wang, X.; Du, Y.; Fan, L.; Liu, H.; Hu, Y. Chitosan- metal complexes as antimicrobial agent: Synthesis, characterization and Structure-activity study. Polym. Bull. 2005, 55, 105–113. [Google Scholar] [CrossRef]
- Katas, H.; Lim, C.S.; Nor Azlan, A.Y.H.; Buang, F.; Mh Busra, M.F. Antibacterial activity of biosynthesized gold nanoparticles using biomolecules from Lignosus rhinocerotis and chitosan. Saudi Pharm. J. 2019, 27, 283–292. [Google Scholar] [CrossRef] [PubMed]
- Lu, B.; Lu, F.; Ran, L.; Yu, K.; Xiao, Y.; Li, Z.; Dai, F.; Wu, D.; Lan, G. Imidazole-molecule-capped chitosan–gold nanocomposites with enhanced antimicrobial activity for treating biofilm-related infections. J. Colloid Interface Sci. 2018, 531, 269–281. [Google Scholar] [CrossRef] [PubMed]

| Nanoparticles | Synthesis Method | Characterization of Synthesized Nanoparticles | Applications | References |
|---|---|---|---|---|
| Ch-silver | Green synthesis of Ch silver bionanocomposite using the plant extract of Saccharum officinarum. | Characterized by UV-vis spectrophotometer, TEM, and FTIR. | Antibacterial applications against Bacillus cereus, Staphylococcus, and Escherichia coli. | [59] |
| Ch-silver | Synthesis of Ch silver bioconjugates using leaf extract of Prunus cerasus. | The bioconjugates were characterized using TEM, DLS, FT-IR, UV–Vis spectroscopy, and a zeta potential analyzer. | Antimicrobial applications E. coli, Enterococcus faecalis, Klebsiella pneumoniae, and S. aureus. | [46] |
| Ch-silver | Biosynthesis of Ch silver nanocomposite using Aloe vera extract and Cuscuta reflexa extract. | Characterized by UV–vis spectrum, FT-IR, and SEM | Antibacterial activities against Staphylococcus aureus ATCC 33592, K. pneumoniae ATCC 13884, Bacillus subtilis ATCC 55614, and E. coli ATCC 11229. | [58] |
| Ch-silver | Green synthesis of Ch silver nanoparticles using vitamin C as a reducing agent. | SEM, Zeta potential, and XRD. | In vitro antimicrobial activities against E. coli and S. Typhimurium, and in vivo antibacterial activity against E. coli in minced beef meat samples. | [60] |
| Ch-silver | Green synthesis of Ch-AgNPs using Ch as a stabilizer and sodium hydroxide as a reducing agent. | UV–vis spectroscopy, FT-IR spectroscopy, XRD, SEM, EDX, and zeta sizer nano. | Antibacterial activity against S. aureus, E. coli, and antifungal activity against Candida albicans. | [61] |
| Ch-silver | Green synthesis by a simple and environmentally friendly in situ chemical reduction process. | UV–Vis, TEM, SEM, XRD, and FTIR. | Antibacterial activity against S. aureus, and E. coli. | [26] |
| Ch-silver | Green and rapid synthesis of Ch-AgNPs using economically abundant biopolymer crustacean waste. | UV–visible spectral, FTIR, XRD, AFM, TEM, and DLS. | Antibacterial activity against Bacillus sp., Staphylococcus sp., Pseudomonas sp., E. coli, Proteus sp., Serratia sp. and Klebsiella sp. Antifungal activity against Aspergillus niger, A. fumigatus, A. flavus, and C. albicans. | [62] |
| Ch-silver | Biosynthesis of AgNPs and Ch-AgNPs using the stem extract of Saccharum officinarum. | Characterized by UV–vis, TEM, SEM, and FTIR. | Antibacterial activity against B. subtilis (MTCC 3053), K. planticola (MTCC 2277), Streptococcus faecalis (ATCC 8043), P. aeruginosa (ATCC 9027), and E. coli (ATCC 8739). | [51] |
| Ch-silver | Biosynthesis of Ch-AgNPs using fungal biomass (Aspergillus fumigatus KIBGE-IB33). | UV–vis, SEM, DLS, and FTIR. | Antimicrobial activity against Enterococcus faecalis ATCC 29212 S. Typhimurium ATCC 3632, Listeria monocytogenes ATCC 7644, and P. aeruginosa ATCC 27853. | [54] |
| Ch-silver | Green synthesis of Ch-AgNPs using Ch as a reducing agent, as well as the stabilizing agent. | UV–Vis, FTIR spectroscopy, TEM, XRD, and DLS. | Antibacterial activity against Gram-positive S. aureus (KMIEV B161), and Gram-negative E. coli. | [63] |
| Ch-silver | The green route was used for the synthesis of Ch-based silver nanoparticles using Ch as a reducing and stabilizing agent. | UV–vis, FTIR, SEM, XRD, and TEM. | Antibacterial activity against P. aeruginosa, E. coli, and methicillin-resistant S. aureus. | [64] |
| Ch-silver | Ch-AgNPs were synthesized using AgNO3, cysteine, and Ch. | UV–vis, DLS and Zeta potential, TEM, and XRD. | Antifungal activity against Sporothrix brasiliensis, and Sporothrix schenckii. | [65] |
| Ch-silver | Biosynthesis of Ch-AgNPs using leaf extract of Cissus arnottiana. | UV–Vis, SEM, TEM, AFM (atomic force microscope), XRD, and SAED. | Antibacterial and antifungal activity against S. aureus, Streptococcus mutans, E. faecalis, and C. albicans. | [53] |
| Ch-silver | Ch ascorbic acid-based green synthesis of polymeric silver nanoparticles. | UV–Vis, TEM, X-ray photoelectron spectroscopy (XPS). | Antibacterial and antifungal activity against S. aureus, P. aeruginosa, E. coli, and C. albicans. | [66] |
| Ch-silver | Green synthesis of Ch-AgNPs using Ch as a reducing agent, as well as the stabilizing agent. | UV–vis, FTIR, XRD, and high-resolution transmission electron microscopy (HRTEM). | Catalytic activity and antibacterial activity against E. coli, and M. luteus. | [67] |
| Ch-silver | Synthesis of biogenic Ch-AgNPs using Ch as a reducing agent, as well as the stabilizing agent. | UV–vis, FTIR, EDX, SEM, TEM, and XRD. | Anticancer activity in human hepatocellular carcinoma HepG2 cells. | [68] |
| Ch-silver | Biogenic synthesis of Ch functionalized silver nanoparticles using leaf extract of Carica papaya. | UV–vis, FTIR, DLS, HRTEM, and zeta potential estimation. | Antibacterial and antibiofilm activities against E. coli, and S. aureus. | [69] |
| Ch-silver | Biosynthesis of AgNPs and Ch-AgNPs using seed extract of Piper nigrum. | UV–vis, XRD, SEM, TEM, and FTIR. | Antibacterial activity against E. coli, and Bacillus subtilis. | [70] |
| Ch-silver and Ch-gold | Biosynthesis of Ch-silver and Ch-gold nanocomposites using Bacillus Subtilis. | UV–vis, XRD, SEM, and TEM. | Antibacterial activity against S. aureus, and P. aeruginosa. Antifungal activity against A. niger, and C. albicans. | [71] |
| Ch-silver and Ch-gold | Biosynthesis of Ch-silver and Ch-gold nanoparticles using two endophytic fungi, Aspergillus sp., and Alternaria sp. | UV–vis, XRD, FTIR, and TEM. | Antibacterial activity against E. coli, and S. aureus. Antibiofilm activity against P. aeruginosa, B. subtilis, E. coli, and S. aureus. | [72] |
| Ch-gold | The AuNPs and Ch-AuNPs have been biosynthesized using the extract of black pepper (Piper nigrum) | UV–vis, DLS, zeta potential, TEM, SAED, and EDX. | Antifilarial activity against Setaria cervi causes filarial parasite disease. | [47] |
| Ch-gold | Ch-AuNPs were synthesized using gold (III) chloride trihydrate and Ch. | UV–Vis, FE-TEM, FE-SEM, Zeta potential, and EDX. | Antifungal activity against C. albicans. | [73] |
| Ch-gold | Green synthesis of Ch-AuNPs using Ch as a reducing and stabilizing agent. | UV–vis, DLS, and TEM. | Antibacterial activity against S. aureus ATCC 29213, S. aureus ATCC 43300, and E. coli 11046. | [29] |
| Ch-gold | Green synthesis of Ch-AuNPs using Ch as a reducing and stabilizing agent. | TEM, SEM, FTIR, and XRD. | Antibacterial activity against P. aeruginosa, and S. aureus. Antifungal activity against C. albicans. | [36] |
Publisher’s Note: MDPI stays neutral with regard to jurisdictional claims in published maps and institutional affiliations. |
© 2022 by the authors. Licensee MDPI, Basel, Switzerland. This article is an open access article distributed under the terms and conditions of the Creative Commons Attribution (CC BY) license (https://creativecommons.org/licenses/by/4.0/).
Share and Cite
Huq, M.A.; Ashrafudoulla, M.; Parvez, M.A.K.; Balusamy, S.R.; Rahman, M.M.; Kim, J.H.; Akter, S. Chitosan-Coated Polymeric Silver and Gold Nanoparticles: Biosynthesis, Characterization and Potential Antibacterial Applications: A Review. Polymers 2022, 14, 5302. https://doi.org/10.3390/polym14235302
Huq MA, Ashrafudoulla M, Parvez MAK, Balusamy SR, Rahman MM, Kim JH, Akter S. Chitosan-Coated Polymeric Silver and Gold Nanoparticles: Biosynthesis, Characterization and Potential Antibacterial Applications: A Review. Polymers. 2022; 14(23):5302. https://doi.org/10.3390/polym14235302
Chicago/Turabian StyleHuq, Md. Amdadul, Md. Ashrafudoulla, Md. Anowar Khasru Parvez, Sri Renukadevi Balusamy, Md. Mizanur Rahman, Ji Hyung Kim, and Shahina Akter. 2022. "Chitosan-Coated Polymeric Silver and Gold Nanoparticles: Biosynthesis, Characterization and Potential Antibacterial Applications: A Review" Polymers 14, no. 23: 5302. https://doi.org/10.3390/polym14235302
APA StyleHuq, M. A., Ashrafudoulla, M., Parvez, M. A. K., Balusamy, S. R., Rahman, M. M., Kim, J. H., & Akter, S. (2022). Chitosan-Coated Polymeric Silver and Gold Nanoparticles: Biosynthesis, Characterization and Potential Antibacterial Applications: A Review. Polymers, 14(23), 5302. https://doi.org/10.3390/polym14235302

